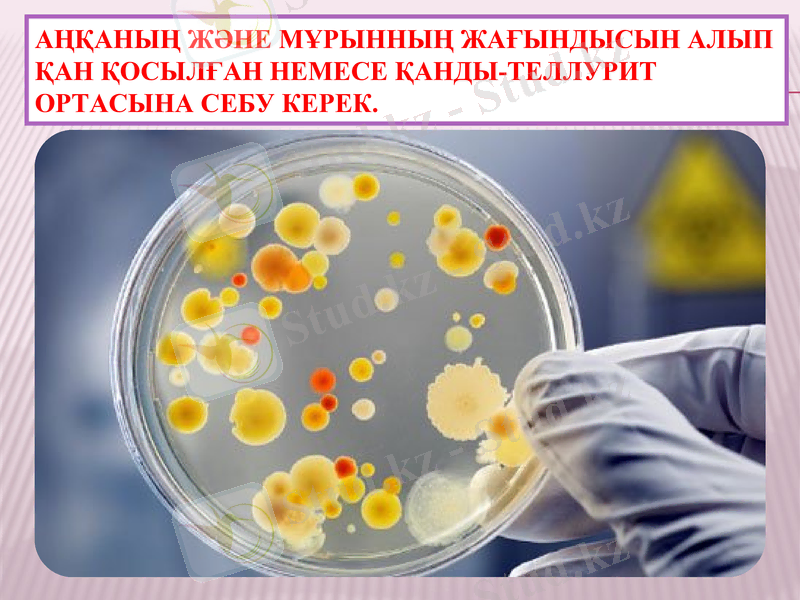
Slide 14

Дифтерия (күл ауруы): этиологиясы, патогенезі, клиникалық белгілері, диагностикасы және емдеу мен алдын алу



“Интердент” медициналық колледжі
Тақырып: Күл (Дифтерия) ауруы
Пән:Жұқпалы аурулар
Тексерген: Бекбатырова Г. Т.
Орындаған: Оразбай Бегзада

Дифтерия
Күл ауруы (дифтерия) -коринебактериялар тобының Леффлер бактериясымен қоздырылатын, ағзаның улану белгілерімен және мұрын, жұтқыншақ шырышты қабықтарының фибринозды қабынуымен сипатталатын жедел жұқпалы ауру.

Этиологиясы
Күл ауруын бактериялардың
токсигенді штаммдары туғызады,
Олар экзотоксин түзеді.
Қоздырғыштың
морфологиялық белгілері: грам оң
таяқша, екі ұшы жуандаған шыны
сауыт (колба) түрінде және жеке
микробтар бір-біріне түйісе рим
сандары ретінде орналасады.
Сау адамдардан бөлінетін дифтерия
таяқшасының токсигенді емес
штаммдары эпидемиялық қауіп
тудырмайды.

Тыныс алу жолдары арқылы кіреді

Эпидемиологиясы
. Күл ауруының көзі - науқас адам. Ең жоғары эпидемиялық қауіпті жұтқыншақ, мұрын және көмей дифтериясымен ауыратын науқастар тудырады, қоздырғыш сыртқы ортаға ауа арқылы бөлінеді. Ал тері дифтериясымен ауыратын науқастардың эпидемиялық қауіпі жағынан маңызы аз. Дифтерия қоздырғышын жұқтырушылардың 5 түрін ажыратады: транзиторлы тасымалдаушылық (қоздырғыш сыртқа ортаға 1-7 күн бөлінеді) ; қысқа мерзімді (7-15 күн) ; орташа ұзақтық (15-30 күн) ; ұзаққа созылатын (6 айға дейін) ; созылмалы (6 айдан артық) . Аурудың берілу механизмі -ауа тамшылы, контагиозды индексі 10-15%.

Патагенезі
Дифтерия қоздырғышының кіру қақпалары болып ағзаның жамылғылары (тері мен шырыштар) есептеледі. Алайда ең жиі ену орындары жұтқыншақтың шырышты қабаты, көмей, мұрын, көздің дәнекер қабығы, жыныс мүшелері, жараның үсті, тері және т. б. Дифтерия экзотоксині бірнеше фракциядан тұрады, олардың әрқайсысы дербес биологиялық әсерлерге ие. Бірінші фракциясы - некротоксин, ол қоздырғыштың кіру орнында эпителий некрозын туғызады, қан тамырларының өткізгіштігін жоғарылатады, Ауыз жұтқыншақтың шырышты көпқабатты эпителиінде дифтериялық қабыну дамып, эпителиіді және дәнекер тіндерді зақымдайды, Екінші фракция - гиалуронидаза, ол жіңішке қан тамырларының құрамындағы гиалуронды қышқылды бұзады да олардың өткізгіштігін жоғарылатады. Таңдай көмекей бездерінің басқа мүшелерден айырмасы, көп ядролы эпителиймен жабылған. Экзотоксиннің үшінші фракциясы - нағыз дифтерия уыты, клетка құрылымынан B цитохромын ығыстырып шығаруға қабілетті. Осы өзгерістерге миокард, жіңішке қан тамырлардың клеткалары және жүйке клеткалары аса сезімтал.

Клиникалық белгілері
Инкубациялық кезең 3-10 күн. Бадамша бездеріндегі жабындылар шектелген, түсі сұр, ақшыл сұр, «+тін» сипатында болады, . Жұтқыншақ дифтериясының таралған түрінде дене қызуы көтеріліп, әлсіздік, терінің бозаруы, ауыздың құрғауы, жұтыну кезіндегі тамақтың ауыруы, көмекей безінің ісінуі, жақ бұрышы лимфа түйіндерінің ұлғаюы және айқын емес ауру сезімі пайда болады. . Дифтерияның типті түрі өз кезегінде жергілікті, таралған, субтоксикалық және токсикалық түрлерге бөлінеді. Сирек, аурудың өте ауыр гипертоксикалық және геморрагиялық түрлері болуы мүмкін. Жұтқыншақ дифтериясының типті түрі. Дифтерияның бұл түрі баяу, сирек жедел басталуы мүмкін. Қызба 37, 5-38◦С, сирек 39◦С, қызбаның ұзақтығы көпке созылмайды (3-5 тәулік) . Дене қызуы қалпына келгеннен кейін де инфекциялық процесс жалғаса береді.

Классификациялық дифтерия
Дифтерия тыныс алу жолдары арқылы:
Дифтерия мұрында- 0. 5%
Дифтерия ротоглоткада-92%
Дифтерия гортанда-1%
Дифтерия трахеяда- 0. 3%
Дифтерия бронхтарда-0. 3%
Дифтерия көзде -0. 3%
Дифтерия құлақта -0. 2%
Дифтерия жыныстық мүшелерде-0. 2%
Дифтерия теріде .


Құлақтағы және жыныс мүшелеріндегі дифтерия


Диагностикасы
Клиникалық және эпидемиологиялық анамнез жинау
Лабораторлық диагностика: Бактериологиялық әдіс. Аңқаның және мұрынның жағындысын алып қан қосылған немесе қанды-теллурит ортасына себу керек.

Серологиялық диагностика: АР, ТГАР, ИФА. ПТР.
Аңқаның және мұрынның жағындысын алып қан қосылған немесе қанды-теллурит ортасына себу керек.

Емі
Дифтериямен ауырған науқастарға антибиотиктер енгізіледі (бензилпенициллин, эритромицин, цефалоспориндер орта терапевтикалық дозамен 5-10 күн бойы) .
спазмолитиктер, седативті препараттар қолданылады (5% седуксен ерітіндісі-2 мл, тәулігіне 3-4 рет) .

Алдын алу шаралары
Дифтерияға қарсы иммунизация шараларын жүзеге асыру.
2 айлық балаларға, 1 ай интервалымен жүргізіледі.
Ревакцинация 6-7 жаста АДС препаратымен
16-17 жаста АДС-М препаратымен жүргізіледі.

Назар аударғандарыңызға
үлкен рахмет!!!
- Іс жүргізу
- Автоматтандыру, Техника
- Алғашқы әскери дайындық
- Астрономия
- Ауыл шаруашылығы
- Банк ісі
- Бизнесті бағалау
- Биология
- Бухгалтерлік іс
- Валеология
- Ветеринария
- География
- Геология, Геофизика, Геодезия
- Дін
- Ет, сүт, шарап өнімдері
- Жалпы тарих
- Жер кадастрі, Жылжымайтын мүлік
- Журналистика
- Информатика
- Кеден ісі
- Маркетинг
- Математика, Геометрия
- Медицина
- Мемлекеттік басқару
- Менеджмент
- Мұнай, Газ
- Мұрағат ісі
- Мәдениеттану
- ОБЖ (Основы безопасности жизнедеятельности)
- Педагогика
- Полиграфия
- Психология
- Салық
- Саясаттану
- Сақтандыру
- Сертификаттау, стандарттау
- Социология, Демография
- Спорт
- Статистика
- Тілтану, Филология
- Тарихи тұлғалар
- Тау-кен ісі
- Транспорт
- Туризм
- Физика
- Философия
- Халықаралық қатынастар
- Химия
- Экология, Қоршаған ортаны қорғау
- Экономика
- Экономикалық география
- Электротехника
- Қазақстан тарихы
- Қаржы
- Құрылыс
- Құқық, Криминалистика
- Әдебиет
- Өнер, музыка
- Өнеркәсіп, Өндіріс
Қазақ тілінде жазылған рефераттар, курстық жұмыстар, дипломдық жұмыстар бойынша біздің қор #1 болып табылады.



Ақпарат
Қосымша
Email: info@stud.kz